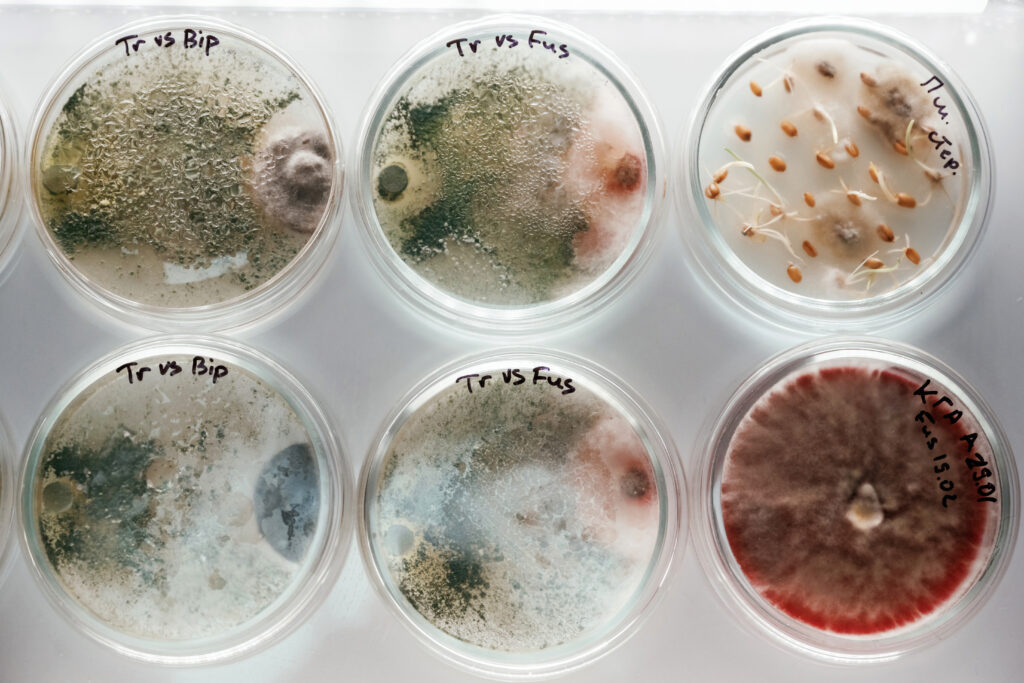

Mold Testing in Los Angeles, CA
Confirm mold presence and type through precise laboratory analysis and sampling methods.
Rapid Mold Testing Services for Homes & Businesses in Los Angeles, CA
Mold testing involves collecting samples from suspected areas and sending them for professional laboratory analysis. This process helps determine the exact type and concentration of mold present in your environment. Accurate testing provides a clear understanding of contamination levels and potential risks. It allows property owners to make informed decisions regarding treatment and next steps. Reports are detailed, easy to understand, and professionally structured. Testing ensures safe and effective remediation planning. It plays an important role in protecting both health and property value. Our process follows industry standards for accuracy. We deliver dependable and timely results for every project.

Schedule Your Professional Mold Inspection Service Today
Don’t let hidden mold affect your health or damage your property.
- Reviews
Our Customer Feedback
CA Mold Inspection did an excellent job inspecting our home. They were thorough, professional, and explained everything clearly. I feel much more confident about the safety of my home now.
Michael R